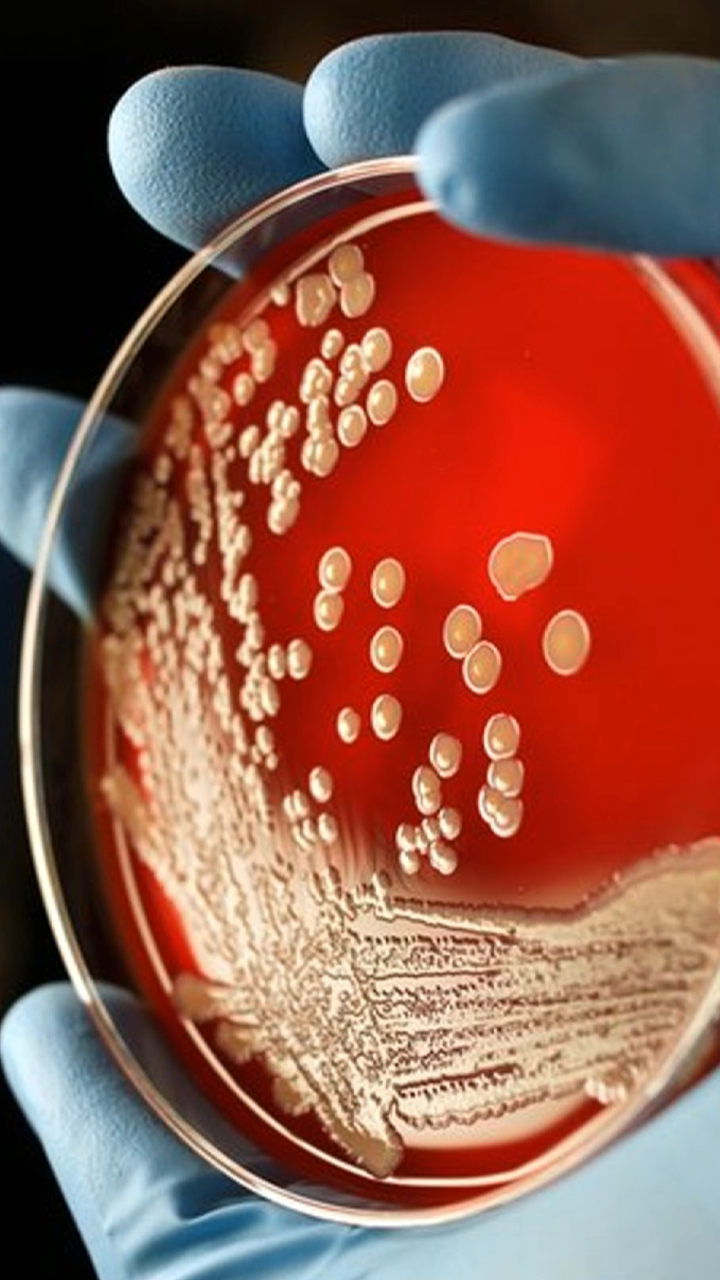
显微镜下的黄色葡萄糖球菌

显微镜下看细菌

显微镜下的手部细菌
图片尺寸1236x929
刷牙很重要!看口腔细菌在显微镜下的模样吧
图片尺寸950x805
显微镜下的黄色葡萄糖球菌
图片尺寸720x1280
显微镜 天台小学三(11)班 季小禾
图片尺寸2000x2666
显微镜观察酸奶中的乳酸菌放大1600倍的乳酸菌
图片尺寸1080x1920
用显微镜发现细菌细胞
图片尺寸700x556
显微镜细菌图片
图片尺寸374x300
显微镜人体皮肤上的细菌图片
图片尺寸920x1302
太恐怖了,看看显微镜下手上的细菌,你还敢饭前不洗手?
图片尺寸661x600
常见细菌可以用普通光学显微镜看到吗?
图片尺寸2048x1536
壁纸 细菌,微生物,在显微镜下看 2880x1800 hd 高清壁纸, 图片, 照片
图片尺寸640x1136
显微镜下的酵母菌(图片来源于网络)
图片尺寸599x493
显微镜细菌图片
图片尺寸363x300
绝美的杀手科学家拍摄显微镜下致命病毒
图片尺寸964x821
电子显微镜下毛骨悚然的牙齿细菌【组图】
图片尺寸687x511
病毒细菌显微镜下高清图片合集ps饭团网
图片尺寸500x800
细菌照片图片-显微镜下的蓝绿菌素材-高清图片-摄影照片-寻图免费打包
图片尺寸800x800
看看显微镜下被放大1000倍牙齿上的细菌
图片尺寸640x480
电子显微镜下的精彩世界!_细菌
图片尺寸620x472
细菌照片图片-显微镜下的蓝绿菌素材-高清图片-摄影照片-寻图免费打包
图片尺寸800x600